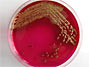

Mais especiais
 Veja as respostas para 10 dúvidas muito curiosas - parte 6
Veja as respostas para 10 dúvidas muito curiosas - parte 6
 Veja as respostas para 10 dúvidas muito curiosas - parte 5
Veja as respostas para 10 dúvidas muito curiosas - parte 5
 Veja as respostas para 10 dúvidas muito curiosas - parte 4
Veja as respostas para 10 dúvidas muito curiosas - parte 4
 Veja as respostas para 10 dúvidas muito curiosas - parte 3
Veja as respostas para 10 dúvidas muito curiosas - parte 3
 Veja as respostas para 10 dúvidas muito curiosas - parte 2
Veja as respostas para 10 dúvidas muito curiosas - parte 2
 Veja as respostas para 10 dúvidas muito curiosas - parte 1
Veja as respostas para 10 dúvidas muito curiosas - parte 1
 Conheça os dez mais assustadores distúrbios do sono
Conheça os dez mais assustadores distúrbios do sono
 Veja como o ator Carmo Dalla Vecchia perdeu 16 quilos para novo trabalho
Veja como o ator Carmo Dalla Vecchia perdeu 16 quilos para novo trabalho
 Saiba consumir bebidas de cores fortes sem manchar os dentes
Saiba consumir bebidas de cores fortes sem manchar os dentes
Entenda e saiba como se proteger da Superbactéria
Entenda e saiba como se proteger da Superbactéria
 Situações que podem causar o ataque de um cão
Situações que podem causar o ataque de um cão
 Revista lista estátuas gigantescas ao redor do mundo
Revista lista estátuas gigantescas ao redor do mundo
 Estrutura e serviços diferem entre aeroportos brasileiros
Estrutura e serviços diferem entre aeroportos brasileiros
 7/7 - veja fotos dos atentados em Londres
7/7 - veja fotos dos atentados em Londres
 Veja 30 crimes que abalaram o Brasil
Veja 30 crimes que abalaram o Brasil
 São Paulo antes e depois - 1958 / 2008
São Paulo antes e depois - 1958 / 2008
 Maior telescópio espacial do mundo faz aniversário
Maior telescópio espacial do mundo faz aniversário
 Candidata, Mulher Melão garante "bastante corpo-a-corpo"
Candidata, Mulher Melão garante "bastante corpo-a-corpo"
 Presa como cafetina, Andréia Schwartz quer ser deputada no ES
Presa como cafetina, Andréia Schwartz quer ser deputada no ES
 Jean Wyllys diz que não usará fama em campanha para deputado
Jean Wyllys diz que não usará fama em campanha para deputado
 'Quero gay, lésbica, homem, mulher, eu quero voto de todo mundo', pede Vampeta
'Quero gay, lésbica, homem, mulher, eu quero voto de todo mundo', pede Vampeta
 Entrevista com Kléber Bambam, candidato a deputado
Entrevista com Kléber Bambam, candidato a deputado
 Conheça os 10 cientistas mais malucos de todos os tempos
Conheça os 10 cientistas mais malucos de todos os tempos
 20 crimes que abalaram o Brasil
20 crimes que abalaram o Brasil
 Conheça os vulcões mais ativos do mundo
Conheça os vulcões mais ativos do mundo
 Os maiores desastres naturais de 2010
Os maiores desastres naturais de 2010
 Os nomes preferidos nos últimos 120 anos
Os nomes preferidos nos últimos 120 anos
 Tsunami, 5 anos depois da tragédia
Tsunami, 5 anos depois da tragédia
 Oscar niemeyer - obras, biografia, curiosidades, cronologia
Oscar niemeyer - obras, biografia, curiosidades, cronologia
 20 anos da queda do muro de-berlim
20 anos da queda do muro de-berlim
 70 anos do início da Segunda Guerra
70 anos do início da Segunda Guerra
 Situação constitucional da América Latina
Situação constitucional da América Latina
 Doenças que voltaram
Doenças que voltaram Como se medem os terremotos
Como se medem os terremotos O caso Bruno
O caso Bruno Cães de Guerra
Cães de Guerra Hubble 20 anos
Hubble 20 anos 40 anos do Homem na Lua
40 anos do Homem na Lua Crimes que abalaram o Mundo
Crimes que abalaram o Mundo Caso Isabella Nardoni
Caso Isabella Nardoni Caso Eloá
Caso Eloá Caso Fritzl
Caso Fritzl O Relógio do apocalipse
O Relógio do apocalipse Festas de ano-novo no mundo
Festas de ano-novo no mundo Forças armadas na América do Sul
Forças armadas na América do Sul Animais se divertem na neve pelo mundo
Animais se divertem na neve pelo mundo
